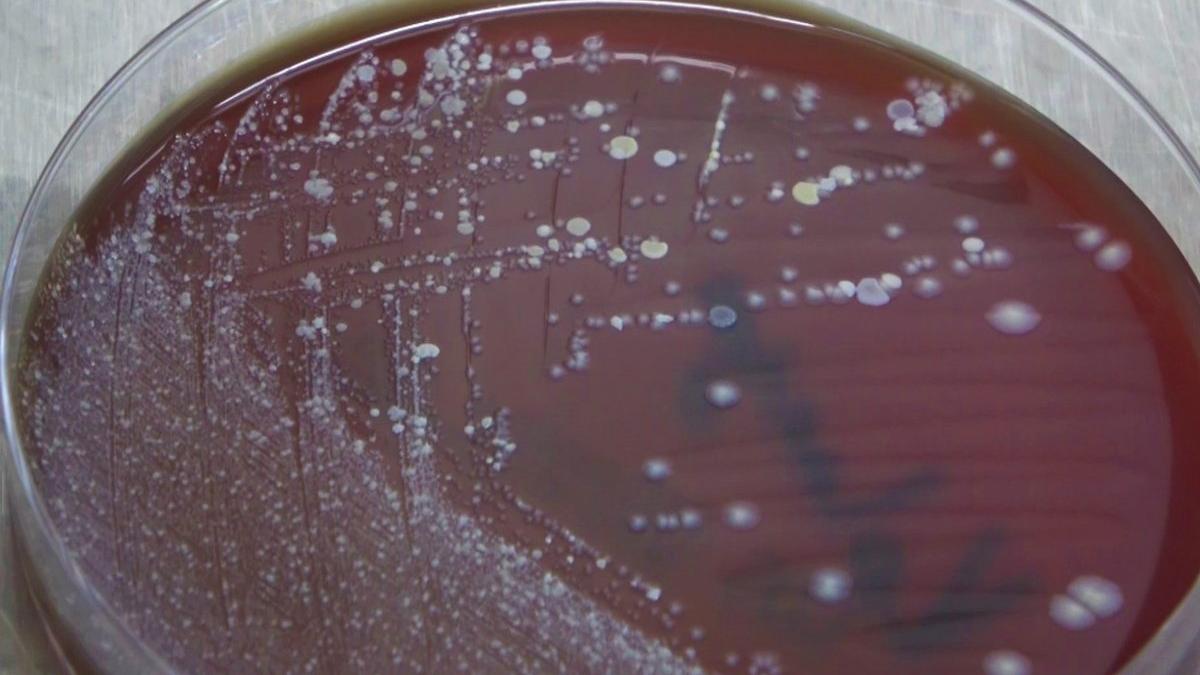
Yıkanan veya kolonya sıkılan maskede korkutan sonuç

Merkeze bağlı Kayadibiçavuş köyünde oturan Şaban Kesim, iddiaya göre dün evde kolonya içti.Görme bozukluğu yaşayan Kesim’in yakınları durumu sağlık ekiplerine haber verdi.Köye gelen sağlık ekipleri tarafından ambulansla hastaneye kaldırılan Kesim, yoğun bakıma alındı.Kesim, yapılan tüm müdahalelere rağmen bugün öğle saatlerinde hastanenin yoğun bakım sevisinde yaşamını yitirdi. Olayla ilgili soruşturma başlatıldı. DHAİlginizi Çekebilir Yıkanan veya kolonya sıkılan maskede korkutan sonuçİlginizi Çekebilir
Yıkanan veya kolonya sıkılan maskede korkutan sonuçİlginizi Çekebilir Dezenfektan ve kolonya ihracatında tarihi rekor
Dezenfektan ve kolonya ihracatında tarihi rekor
Yıkanan veya kolonya sıkılan maskede korkutan sonuçİlginizi Çekebilir
Yıkanan veya kolonya sıkılan maskede korkutan sonuçİlginizi Çekebilir Dezenfektan ve kolonya ihracatında tarihi rekor
Dezenfektan ve kolonya ihracatında tarihi rekor 





